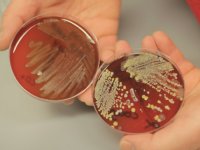

Artikelen: resistentie
Overzichtspagina artikelen: 'resistentie' op Varkens.nl. Voor overige onderwerpen kunt u onze zoekfunctie (rechtsboven) gebruiken.
-
'Als je het snapt, doe je het beter'
25-08-2025 - Het zou zomaar een van de legendarische Cruijffiaanse uitspraken kunnen zijn. Dat is het niet, maar toch: beter goed gejat dan slecht verzonnen. Het over de schutting kijken brengt je nogal...
-
Resistentie antimicrobiële middelen blijft hoog bij mens en dier
06-03-2025 - Resistentie tegen antimicrobiële middelen die veel worden gebruikt, zoals ampicilline, tetracycline en sulfonamiden, blijft hoog bij mensen en dieren voor belangrijke pathogenen, waaronder...
-
Flinke daling antibioticagebruik stemt tot tevredenheid
26-08-2023 - In vrijwel alle diersectoren is het antibioticagebruik in 2022 verder gedaald. In de varkenssector is die daling in 2022 maar liefst 23,8 procent. De inzet en aanpak door de dierenartsen en...
-
Korter diertransport geeft minder risico op overdracht resistente bacteriën
26-10-2022 - Maatregelen als het verminderen van de transportduur van dieren en het goed reinigen van voertuigen en materieel kunnen de overdracht van resistente bacteriën tijdens veetransport...
-
Onderzoek naar verspreiding resistente kiemen tijdens veetransport
26-10-2021 - De invloed van veetransport op de verspreiding van kiemen met een antimicrobiële resistentie wordt onderzocht door de Europese Autoriteit voor Voedselveiligheid (Efsa). Onder de loep liggen...
-
Geen verbod op kritische antibiotica
16-09-2021 - Het Europarlement wil geen verbod op het gebruik van kritische antibiotica voor dieren. Met ruime meerderheid verwierp het parlement een motie van de Europese Groenen waarin werd...
-
Meer ESBL bij dierenartsen en dierenartsassistenten
05-03-2021 - Bij dierenartsen en dierenartsassistenten komen meer ESBL-producerende bacteriën voor. Dat is niet te relateren aan een bepaalde diersoort. Wel heeft 69 procent van deze veterinaire...
-
Spenen en PRRS hebben effect op resistentie
09-09-2020 - Resistentie van bacteriële ziekteverwekkers tegen antibiotica is niet alleen het gevolg van antibioticagebruik. Eerste resultaten van een groot onderzoek in de Verenigde Staten laten zien...
-
Resistentie gaat goede kant op
29-06-2020 - De resistentieniveaus bij de verschillende bacteriën dalen verder of stabiliseren. Dat is mooi in lijn met de daling van het antibioticagebruik. Bij E. coli is voor het eerst geen...